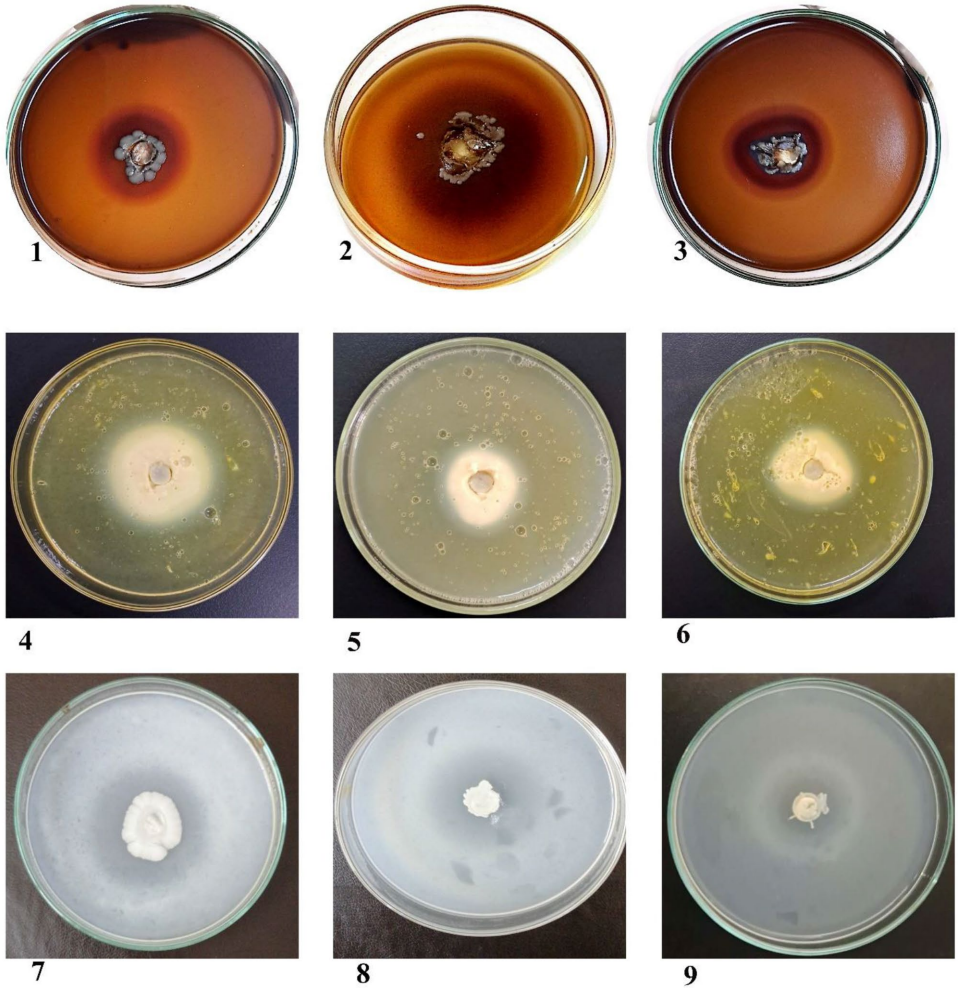

-
生物通官微
陪你抓住生命科技
跳动的脉搏
新生儿鹅口疮相关酵母菌的毒力特征与分子鉴定研究
【字体: 大 中 小 】 时间:2025年06月27日 来源:BMC Microbiology 4
编辑推荐:
本研究针对新生儿鹅口疮的致病机制,通过形态学和分子生物学技术鉴定了79例临床分离株中Candida albicans等11种酵母菌的分布特征,发现51.9%为C. albicans,并首次在埃及报道Trichosporon asahii致病案例。研究证实PLB1和SAP1基因与水解酶活性显著相关,为临床诊疗提供新依据。论文创新性应用(CALB1-CALB2)特异性引物区分C. albicans与C. dubliniensis,发表于《BMC Microbiology》。
新生儿鹅口疮作为常见的口腔黏膜感染,严重威胁着早产儿和低体重儿的健康。尽管已知Candida albicans是主要病原体,但非白色念珠菌的致病机制仍存在认知空白。更棘手的是,传统鉴定方法难以区分形态相似的C. albicans和C. dubliniensis,且水解酶等毒力因子的分子机制尚未阐明。这些知识缺口直接影响临床诊断准确性和治疗策略的制定。
针对这些问题,南谷大学的研究团队开展了一项创新性研究,系统分析了ICU新生儿口腔样本中酵母菌的分布特征和致病机制。研究团队从172例临床样本中分离出79株酵母菌,采用多维度技术揭示了病原谱系和毒力特征。论文发表在《BMC Microbiology》杂志,为新生儿真菌感染的诊疗提供了重要依据。
研究主要运用了以下关键技术:1)基于Chromogenic和HiChrome培养基的形态学鉴定;2)CALB1-CALB2特异性引物PCR区分C. albicans;3)CandF-CandR通用引物PCR结合ITS测序鉴定其他菌种;4)卵黄平板法检测磷脂酶活性;5)酪蛋白水解实验评估蛋白酶活性;6)PLB1和SAP1基因的PCR检测。
【研究结果】
【背景】研究团队首先明确了新生儿鹅口疮的高危因素,发现早产(54例)和低体重(15例)是主要住院原因,这为后续病原分析提供了临床背景。
【材料与方法】通过Sabouraud培养基从172例样本(93男/79女)分离出79株酵母菌,创新性地组合应用三种分子技术:特异性引物PCR(CALB1-CALB2)、通用引物PCR(CandF-CandR)和ITS测序,确保鉴定准确性。
【形态学特征】PCA分析显示,53株菌落呈现典型C. albicans特征(灰色圈),而18株非白色念珠菌表现出颜色变异(黑色圈)。值得注意的是,5株无法通过显色培养基鉴定的菌株,经分子技术确认为罕见病原体。

【分子鉴定】特异性引物PCR显示41株为C. albicans(273bp条带),12株C. dubliniensis需通过810bp条带和测序确认。系统发育分析表明,C. dubliniensis(PP475382等)与C. albicans(KC422432.1)形成独立分支(bootstrap值99%)。
【毒力特征】研究发现36株(45.6%)同时产溶血素、磷脂酶和蛋白酶。特别值得注意的是:
【基因检测】PLB1基因在64株(81%)中检出,其中45株(57%)同时表现磷脂酶活性。SAP1基因在33株(41.8%)中检出,32株伴有蛋白酶活性。这首次证实了基因型与表型的关联规律。
【讨论与结论】
该研究取得了三个重要突破:首先,建立了CALB1-CALB2/CandF-CandR/ITS测序的三步鉴定体系,成功解决了C. albicans与C. dubliniensis的鉴别难题。其次,首次在埃及发现Trichosporon asahii引起新生儿鹅口疮的案例,扩展了对病原谱的认知。第三,阐明了PLB1/SAP1基因与水解酶活性的相关性,为毒力机制研究提供新靶点。
研究揭示了C. albicans通过SAP1-10基因家族和PLB1/PLB2基因协同作用,产生多种水解酶破坏宿主屏障。特别值得注意的是,非白色念珠菌如C. parapsilosis虽不携带SAP1基因,仍能通过其他SAPs产生强蛋白酶活性,这解释了其临床致病性。
该成果对临床实践具有重要指导意义:一方面,建立的分子鉴定流程可提高诊断准确性;另一方面,PLB1/SAP1可作为毒力标志物,指导重症患者的个体化治疗。未来研究可进一步探索其他SAPs和PLBs基因的功能,为开发新型抗真菌药物提供理论依据。
生物通微信公众号
知名企业招聘